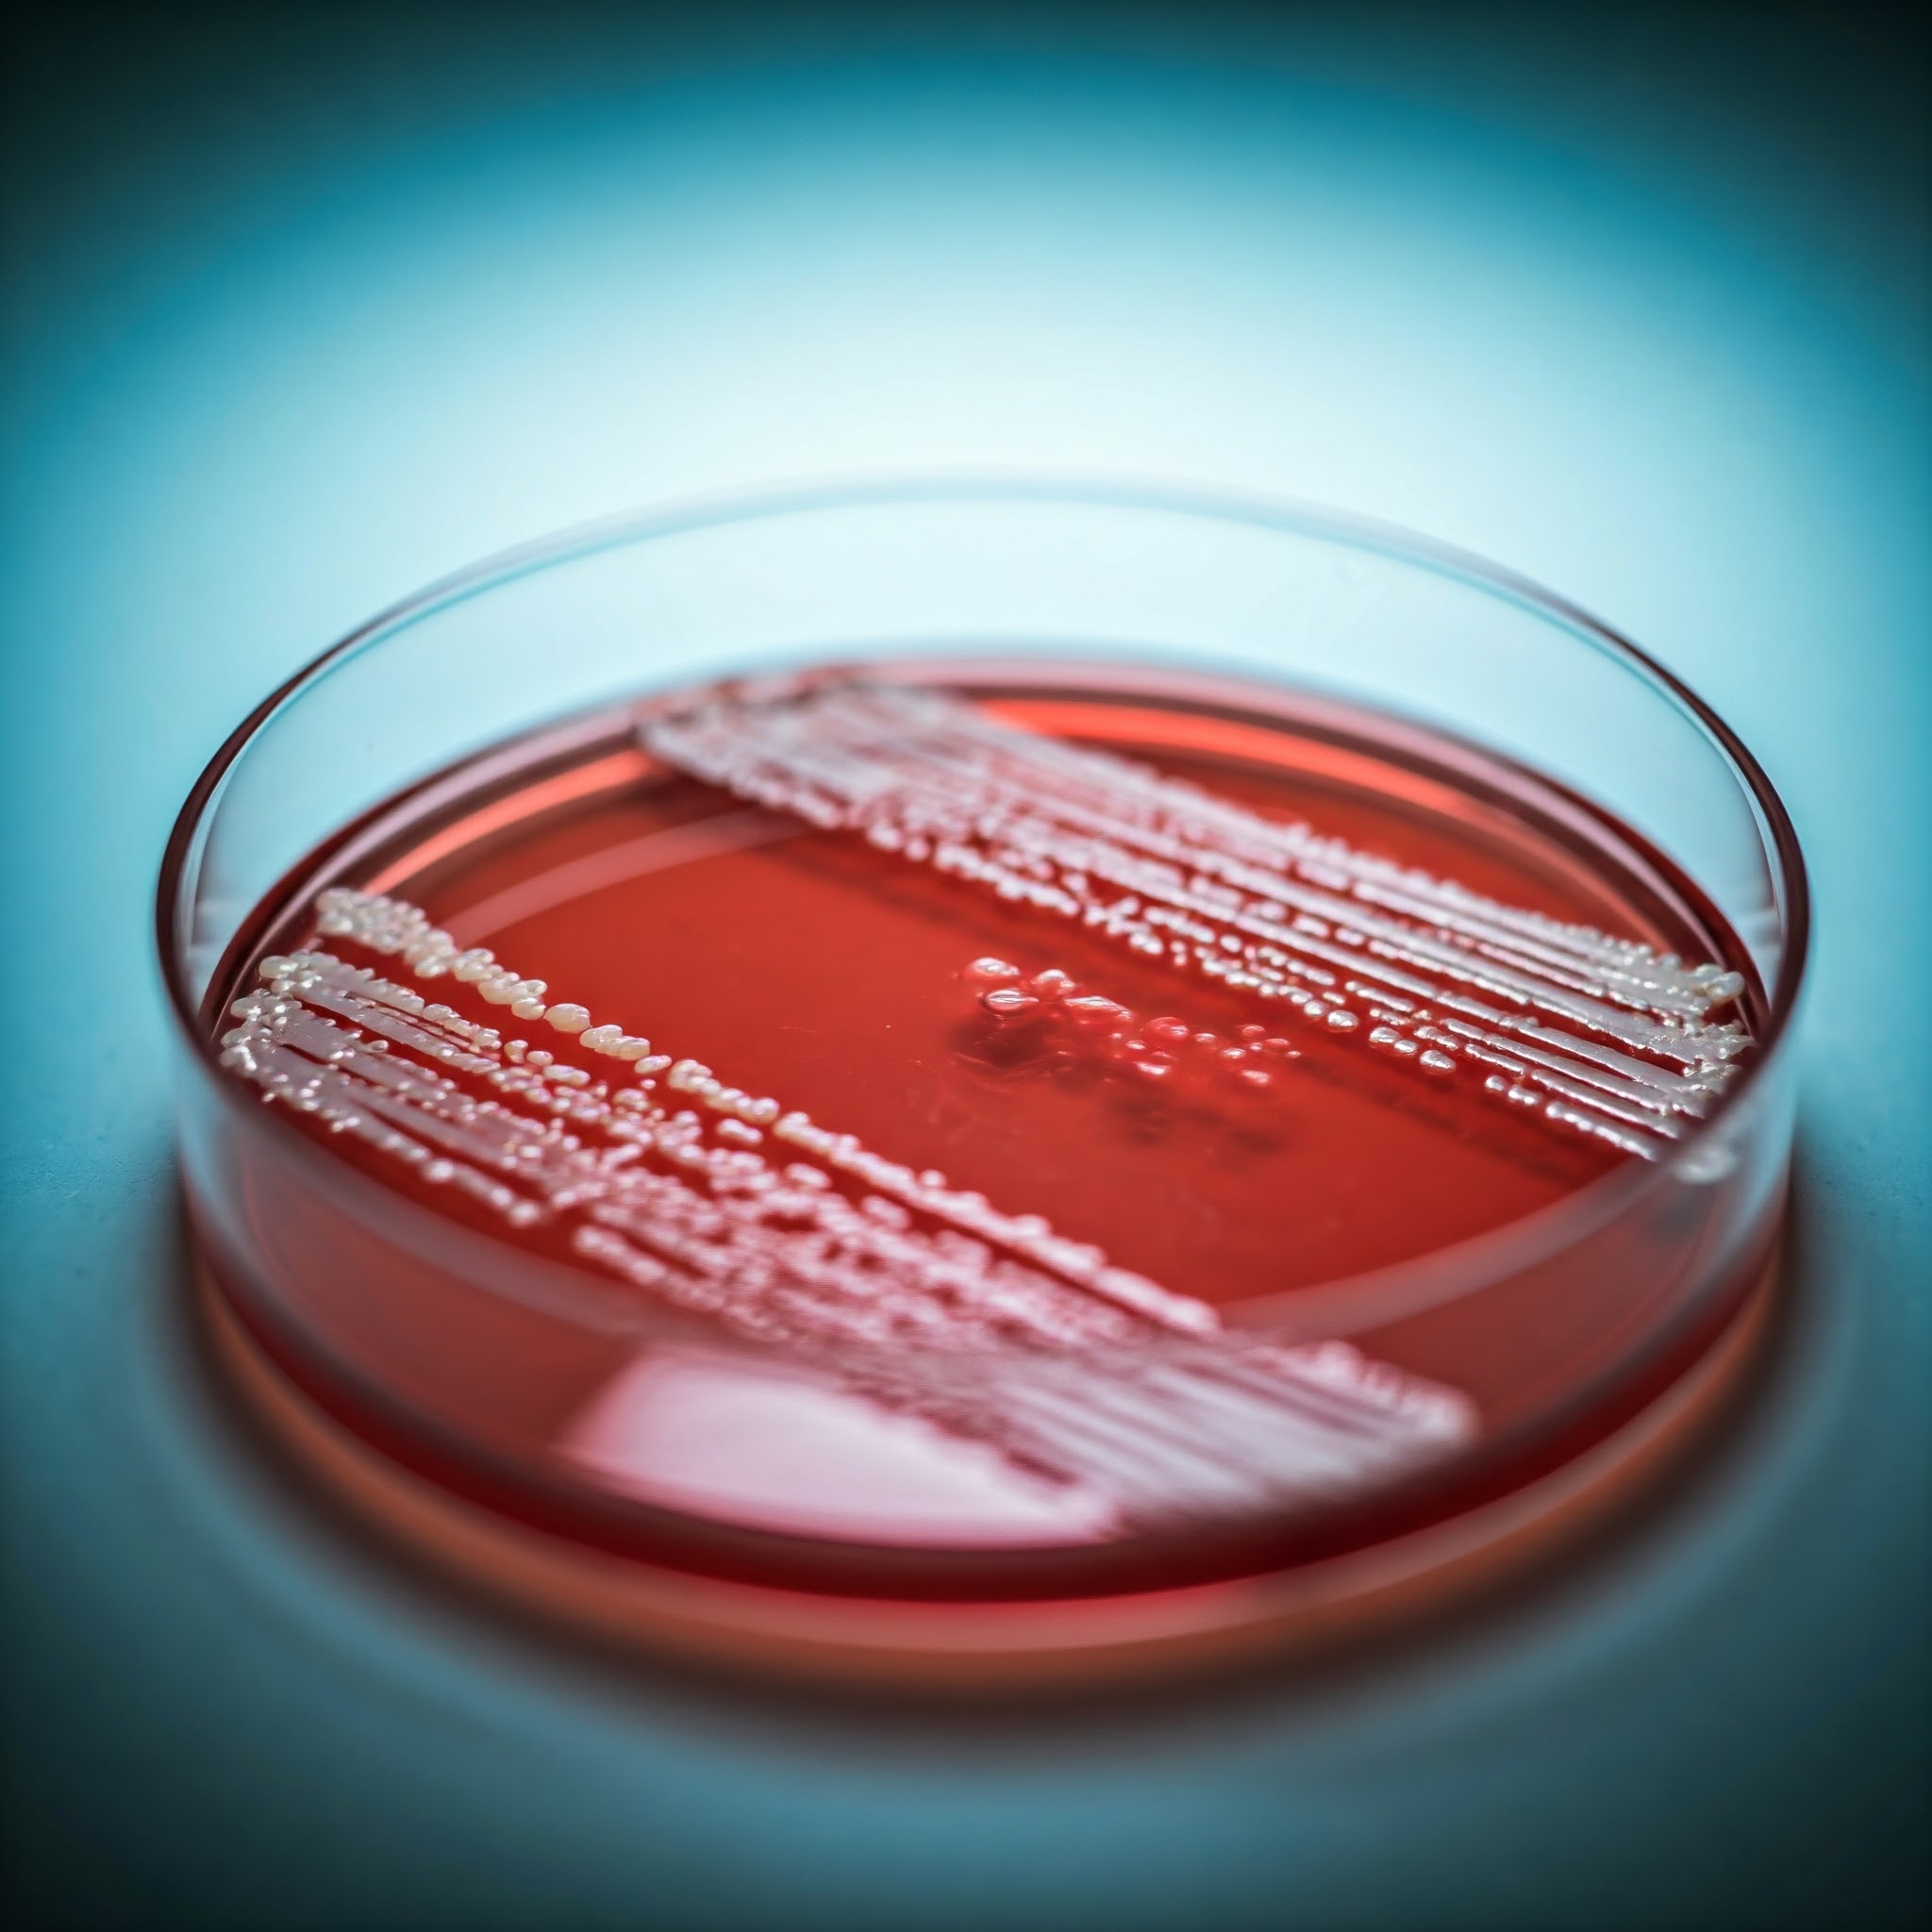
s. aureus culture representation

One of the main causes of skin and soft tissue infections that can occasionally result in sepsis and toxic shock syndrome is Staphylococcus aureus (S. aureus). The rise of methicillin-resistant Staphylococcus aureus bacterium (MRSA) in recent years has exacerbated the microbe’s serious threat to public health.
It is a pathogen in dire need of control because it causes significant morbidity and mortality not just in the United States, but worldwide.
George Liu
However, while being successful in animal models, some 30 clinical trials have not yet produced a successful S. aureus vaccination for humans. Researchers from UC San Diego have now pinpointed a major cause of these failures, suggesting that the vaccines might be adaptable to human use.
Their findings were published in the journal Journal of Clinical Investigation (JCI).
Researchers from UC San Diego School of Medicine also discovered that an excess of IL-10 produced in response to S. aureus inhibits helper T cells’ capacity to combat the infection in a similar study that was published the same day in Nature Communications.
For a bacterium to readily live in our nose and gut, it needs to develop a strategy that effectively dampens the immune response to be able to survive.
George Liu
S. aureus colonizes most of us during infancy and travels through our nasal passages. It doesn’t hurt us most of the time. However, a prior work conducted in 2022 under the direction of assistant project scientist Chih-Ming Tsai, Ph.D., in Liu’s lab, shown that this early exposure deceives our immune cells into generating altered antibodies that are unable to mount a successful defense against S. aureus. Additionally, the bacteria have a “memory” of those non-protective antibodies that they may use in subsequent infections.
According to Tsai, this is the reason why vaccine candidates that have been effective in mice that have never seen the pathogen before have not been able to shield people from fresh S. aureus contacts.
But when the researchers replicated our early encounter with the germs by exposing mice to human S. aureus antibodies prior to inoculation, the vaccine stopped working.
Tsai, Liu, and their colleagues aimed to determine what makes the S. aureus antibodies ineffective against the pathogen following immunization in the JCI research. After exposing the mice to S. aureus, the researchers administered the Iron Surface Determinant B (IsdB) vaccine, which has been demonstrated to provide immunity against S. aureus in mice that had never encountered the germ before.
The researchers discovered that after being exposed to S. aureus twice, B cells, which are white blood cells that produce antibodies, release a large amount of IL-10. The enzymes in the B cells are instructed by IL-10 to add sialic acid, a sugar, to the Fc region of the antibodies, which is in charge of producing the proper immune response. With the sugar in abundance.
The IL-10 is helping make tons of this sugar type and by doing so, it’s turning off our immune system,
The same vaccine that didn’t work before now works perfectly in mice.
Chih-Ming Tsai
The Nature Communications study, which was headed by first author Irshad A. Hajam, Ph.D., an assistant project scientist in Liu’s lab, investigated the interactions between S. aureus and CD4+ T lymphocytes, also referred to as helper T cells, whereas the JCI study concentrated on the function of IL-10 in B cells. These white blood cells are responsible for identifying infections and triggering the attack and destruction of pathogens by other immune cells.
In mice previously exposed to and subsequently vaccinated against S. aureus, the researchers discovered that helper T cells, like B cells, release an excess of IL-10 in response to S. aureus.
Interleukin-17 (IL-17A), a cytokine that is especially useful in combating S. aureus infections, is produced by helper T cells but is inhibited by IL-10. However, the researchers were able to restore IL-17A levels by inhibiting IL-10 or adding a chemical called CAF01, which is known to improve vaccination efficacy by enhancing T cell response to microbial infections.
Adding CAF01 during vaccination helped turn the ineffective IsdB vaccine into one that worked in S. aureus-exposed mice,
Surprisingly, it also worked with several other failed vaccines against S. aureus.
Irshad A. Hajam
Also Read: Future pandemics could be avoided with the use of a novel class of antivirals
The development of a vaccine against S. aureus in humans may benefit from the results of both research. Liu argues that by inhibiting IL-10 or increasing IL-17A during vaccination, it would be possible to make previously designed but unsuccessful S. aureus vaccines more effective. He continues by saying that the creation of IL-10 by several additional microorganisms, such as Clostridium difficile and malaria, may be the cause of the failure of promising vaccinations for these diseases in human clinical trials. He suggests that suppressing the cytokine may also help these vaccines regain their effectiveness.
Source: UC San Diego Today
Journal Reference: Tsai, Chih-Ming et al. “Pathobiont-driven antibody sialylation through IL-10 undermines vaccination.” The Journal of clinical investigation vol. 134,24 e179563. 16 Dec. 2024, DOI: 10.1172/JCI179563.
Last Modified: